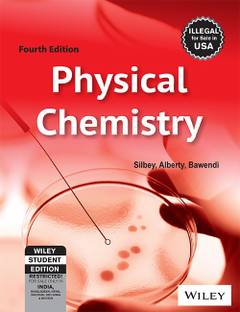

Physical Chemistry 3rd Edition (English, Paperback, Castellan G. W.)
Physical Chemistry 3rd Edition (English, Paperback, Castellan G. W.)
- Language: English
- Binding: Paperback
- Publisher: Narosa Publishing House
- Genre: Science
- ISBN: 9788185015590, 8185015597
- Edition: 3rd, 2004
- Pages: 1046
- Cash on Delivery available?
Physical chemistry is the quantitative study of the physical properties of matter, including their transformations. The properties of macroscopic matter at equilibrium (such as the relationships among temperature, pressure, and volume in gases; heat capacity of solids; solubility of saturated solutions; melting and boiling temperatures; and behavior of electrolyte solutions, to name a few) are historically among the earlier interests of physical chemistry. All of the examples mentioned just above belong to the subject of thermodynamics, a remarkable science which unified a wide variety of empirical laws under the broader concepts of energy and entropy.
| Imprint |
|
| Publication Year |
|
| Edition Type |
|
| Book Type |
|
| Degree/Diploma |
|
| Specialization |
|
| Subject |
|
| Term |
|
- 5★
- 4★
- 3★
- 2★
- 1★
- 50
- 16
- 10
- 1
- 3
good book
sabir papai
Certified Buyer, Kolkatta
Feb, 2015
Excellent
Flipkart Customer
Certified Buyer, Gorakhpur
May, 2024
Just wow!
Flipkart Customer
Certified Buyer, New Delhi
Oct, 2019